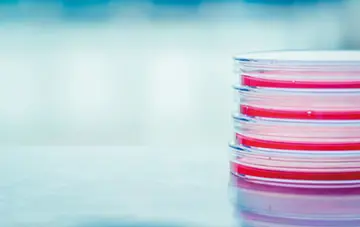

شماره ۱۱۴۴
آزمایشگاه - صفحه 3
شماره ۱۱۳۲
شماره ۱۱۳۰
شماره ۱۱۲۵
بنابر اظهارنظر تیم تحقیق، چنین روشی نهتنها میتواند بیماری آسم را تشخیصدهد، بلکه قادر است شدت و همچنین روند پیشرفت آن را نیز تعیینکند.
شماره ۱۱۲۳
شماره ۱۱۱۹
شماره ۱۱۱۸
شماره ۱۱۱۶
شماره ۱۱۱۶